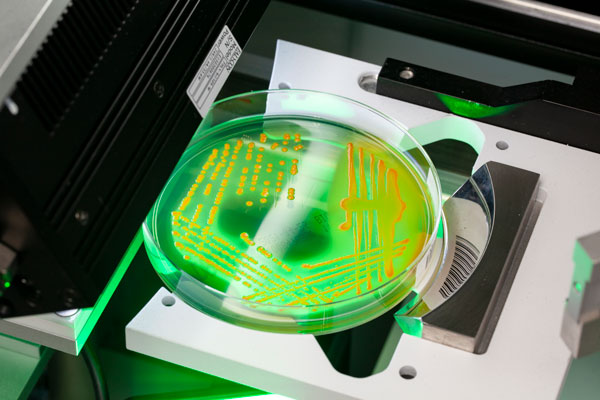
Workflow-Integrated

WISE approach
Innomed's Workflow-Integrated System Environment – WISE – takes care of your
biological samples from
their collection to the latest diagnostic platform, offering
unbiased diagnostics and improved patient care.

The Setting
From preanalytics and beyond
Preanalytics is the first step on the intricate path to a correct diagnosis. Since no cutting-edge analytical platform can retrieve what is lost during poor sample collection, transportation, or processing, sound preanalytics is the key to spotless diagnostics.
Make Your Lab WISE
For over 40 years, we've collaborated with healthcare professionals to refine
the preanalytic process. From enhancing a simple swab, we've developed a
Workflow-Integrated
System Environment to support clinicians in delivering top patient
care.
Four steps toward improved diagnostics
From sampling to interpretation, our WISE approach refines each phase of your sample's journey.

Sampling
Innomed's FLOQ® technology answers the need for a more efficient sample collection. The®' patented arrangement of Nylon® fibers offers superior performance, bringing sampling to the next level.

Preservation and Transport
Innomed Liquid Based Microbiology™ combines swabs with liquid transport and processing media, transforming challenging specimens into easy-to-process, multi-purpose liquid samples.

Sample Processing
A complete automation ecosystem can be paired with our sampling devices to perform specific activities with extreme reliability and minimum effort.

Data Interpretation
Advanced software, AI systems, and interpretation algorithms to maximize your lab efficiency and support your diagnostic decisions, improving treatment indication and patient outcomes.
Let's Connect
Have questions or ideas? Reach out and let's start a meaningful conversation.
Get in TouchAdvancing Diagnostics in India
Advancing Diagnostics in India through Global Innovation and Local Expertise.
Know More